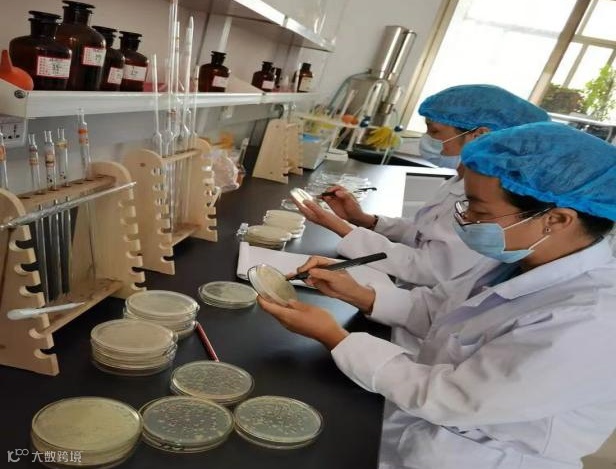

什么是有机肥?


























商品有机肥有什么特点?


























农家肥有什么特点?
















有机肥是臭味越大越好吗?


























如何快速判断有机肥质量的好坏?

有机肥能快速培肥土壤吗?




































有机肥有哪些关键指标?




































有机肥指标受哪些因素影响?




图/文:顺丰洱海环保股份收集部一钟贤玲
周纪斌
责任编辑:杨进成




